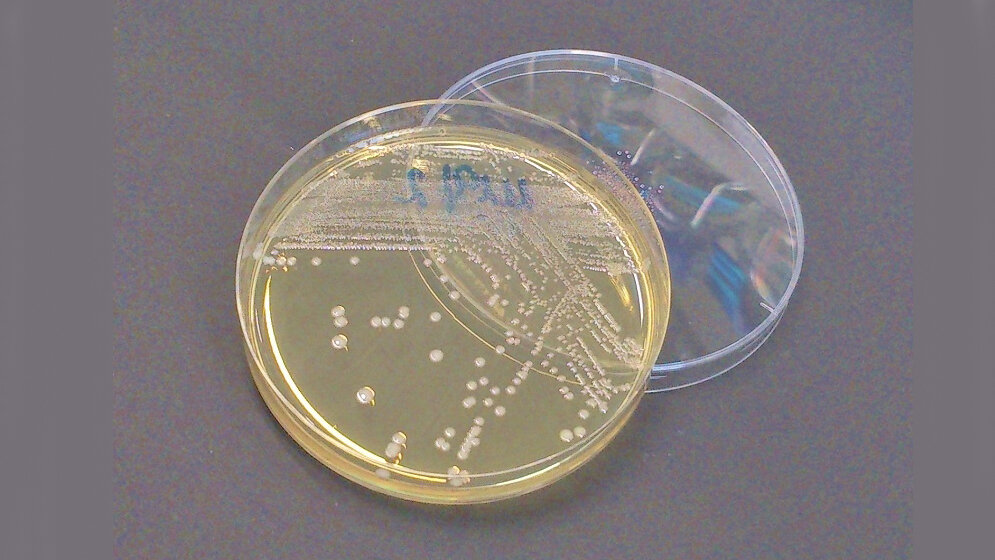
Multiresistente Bakterien

Das Gen mcr-1 macht Darmbakterien unempfindlich für das Reserve-Antibiotikum Colistin. Als letzte Therapiemöglichkeit wird es gegen gefürchtete multiresistente Keime vor allem in Kliniken eingesetzt. Bakterien mit diesem Resistenzgen wurden Anfang des Jahres in Deutschland, vor kurzem nun auch bei einer Patientin in den USA gefunden. Wissenschaftler des Deutschen Zentrums für Infektionsforschung (DZIF) und der Justus-Liebig-Universität Gießen (JLU) haben nun untersucht, wie übertragbar dieses Gen ist. Sie fanden unter anderem heraus, dass das mcr-1-Gen nicht nur auf den beweglichen Plasmiden vorkommt, sondern auch in das Chromosom integrierbar ist. Und damit stabil an die Nachkommen weitervererbt wird.
Breitet sich Colistin-Resistenz aus?
Die Medien sprachen vom „Superkeim“, als vor kurzem bei einer Patientin mit einem Harnwegsinfekt ein E. coli-Keim gefunden wurde, der unter anderem auch das Resistenzgen mcr-1 trug. Das Gen ist bei Nutztieren längst weit verbreitet; dass es nun auch beim Menschen vorkommt, gibt Anlass zur Sorge. „Einige gramnegative Erreger, wie zum Beispiel bestimmte Escherichia coli-Stämme, sind gegen die neueren Breitband-Antibiotika resistent geworden. Hier hilft oft nur das Reserve-Antibiotikum Colistin“, erklärt Dr. Linda Falgenhauer, DZIF-Wissenschaftlerin an der Justus-Liebig-Universität Gießen und Erstautorin der aktuellen Studie. Wenn auch dieses Mittel versage, sei eine Behandlung zusätzlich erschwert.
Doch wie groß ist die Gefahr einer weiteren Ausbreitung der Colistin-Resistenz? Bisher weiß man, dass mcr-1 über Plasmide, bewegliche genetische Elemente, übertragen wird. Diese Übertragbarkeit hat bereits dazu geführt, dass das Gen in vielen Bakterienarten zu finden ist. Offensichtlich ist es in der Lage, zwischen unterschiedlichen Plasmiden zu „springen“ und so die Artengrenze zu überschreiten. Nun befürchten die Wissenschaftler, dass diese Sprunghaftigkeit auch vom Plasmid zum Chromosom stattfinden könnte.
„Wenn das Gen in das Chromosom von Bakterien springt, stellt das eine besondere Gefahr dar“, erklärt Linda Falgenhauer. Denn in diesem Fall könne die Resistenz gegen Colistin stabil auf die Nachkommen vererbt werden. Wenn diese chromosomale Resistenz dann bei Bakterien eintritt, die zwischen Mensch und Tier, zum Beispiel über den Verzehr von Lebensmitteln zirkulieren, wäre ein Reservoir für resistente Keime geschaffen, das über Generationen erhalten bleibt.
Resistenzen können vererbt werden
Genau dieses Ereignis ist bereits eingetreten, fanden die Gießener Forscher heraus. In ihrer aktuellen Publikation beschreiben sie einen multiresistenten E. coli-Stamm des Sequenztyps ST410, der bereits seit Jahren in Mensch und Tier, Umwelt und Lebensmitteln in Deutschland verbreitet ist. Dieser Stamm, so die Entdeckung, enthält neben dem ESBL-Gen, das gegen Betalaktam-Antibiotika mit erweitertem Wirkspektrum resistent macht, auch das mcr-1-Gen auf dem Chromosom, das eine Unempfindlichkeit gegenüber Colistin hervorruft. Beide Gene können über Generationen hinweg vererbt werden. Somit stellt dieses Bakterium ein stilles Reservoir für diese Antibiotika-Resistenzen dar.
Der Nachweis dieses E. coli-Stamms ST410 ist ein Hinweis darauf, dass es bereits mcr-1-kodierende Bakterien gibt, die bei Mensch und Tier zirkulieren und somit viel einfacher als bisher beschrieben übertragen werden können.
In dem aktuellen Projekt haben die DZIF-Wissenschaftler mit Projektpartnern aus dem Forschungsverbund RESET zusammengearbeitet, der sich der Erforschung von Resistenzen gegen Antibiotika in Enterobakterien verschrieben hat. „Das Forscherteam vereint Expertisen aus wissenschaftlichen Instituten und dem öffentlichen Gesundheitsdienst. Durch diese interdisziplinäre Zusammenarbeit verfolgen wir den One-Health-Ansatz, der die systemischen Zusammenhänge von Mensch, Tier, Umwelt und Gesundheit mit einbezieht, um Antibiotika-Resistenzen zu bekämpfen“, so Prof. Dr. Trinad Chakraborty, Direktor Instituts für Medizinische Mikrobiologie an der JLU in Gießen und Koordinator am DZIF-Standort Gießen-Marburg-Langen. (idw, red)
1. Falgenhauer L et al.: Chromosomal location of both mcr-1 and blaCTX-M-15 in fluoroquinolone-resistant Escherichia coli ST410. Emerging Infect Dis., 22 (9), 2016. [Ahead of print], DOI: 10.3201/eid2209.160692
2. Falgenhauer L et al.: Circulation of clonal populations of fluoroquinolone-resistant CTX-M-15-producing Escherichia coli ST410 in humans and animals in Germany. Int J Antimicrob Agents, 47 (6): 457–465, 2016. DOI: 10.1016/j.ijantimicag.2016.03.019
Artikel teilen